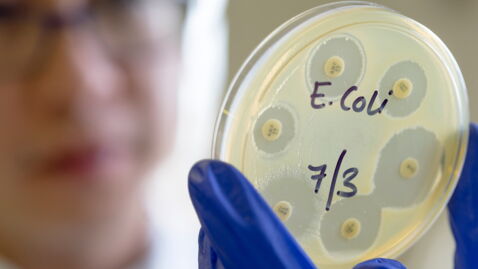
thumbnail

McDonald's Happy Meals caused grave illnesses in children, lawsuit claims

Some parents in Alabama have filed a lawsuit against McDonald’s with the claim that food served by the company caused some serious infections in their children.
Eating contaminated food can have serious, and sometimes, even deadly consequences for people. This is why individuals and restaurants serving food to people need to be aware of, and abide by proper norms of hygiene and food safety. But turns out even giant food corporations like McDonald's are not immune from allegations of spreading deadly infections through their food.
Discover our latest podcast
As reported by AL.Com.,a lawsuit has been filed against McDonald’s in Alabama by some parents who allege that McDonald’s food caused their children to be infected by the deadly E.coli bacteria.
More under this adMore under this ad
McDonald’s Happy Meals causing infection?
The current lawsuit was filed by an attorney, Ben Locklar on behalf of the children’s mothers, Emily Puckett, Kristen Meek and Ashley Myers.
More under this adMore under this adAs per the lawsuit, six children from three different families contracted E.coli infection after eating at a McDonald’s restaurant in Ashland in Clay County.
The illnesses owing to this was so serious that they needed to be hospitalised in Birmingham. This incident happened around March and April after they visited the fast-food restaurant in Ashland in Clay County.
More under this adMore under this adThe samples collected for the children after they fell gravely ill showed positive for E.coli and that the origin of the bacteria was from the same source.
Lawsuit against the McDonald’s franchise
The lawsuit is filed against Deck Foods Inc., a franchise that operates many McDonald’s restaurants in Alabama. As per the suit, even the Alabama Department of Public Health which inspected the restaurant found numerous violations of food safety and health codes.
The attorney for the families, Locklar is quoted by the report as saying,
Our clients, like many others who visited the restaurant during the end of March and beginning of April, expected the food they purchased for their children from McDonald’s to be safe, but it wasn’t.More under this adMore under this ad
After eating Chicken McNuggets Happy Meals, our clients’ children became ill resulting in four of the children being hospitalized with a potentially life-threatening condition.
Sources used:
AL.Com: Alabama McDonald’s McNugget Happy Meals exposed children to E.coli, lawsuit claims